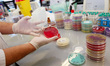
Similar photo #5386770

Click image to zoom
Infectious Diseases Unit In France
Workers in an infectious disease analysis and treatment unit in a hospital in Douai, France, on January 2, 2013. (Photo by Thierry Thorel/NurPhoto)
Photo Details
| Photo ID | #5386758 |
|---|---|
| Date Taken | |
| Location | N/A |
| Photographer | Thierry Thorel/NurPhoto |
| Category | Health |
| Copyright | © 2026 NurPhoto - Thierry Thorel/NurPhoto |
Related Keywords
2026 NurPhoto. All rights reserved.
This image is the property of NurPhoto and is protected under international copyright laws.